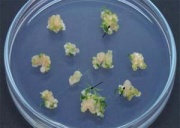

Список файлів
Ця спеціальна сторінка показує всі завантажені файли.
| Назва | Мініатюра | Розмір (в байтах) | Користувач | Опис | Версії | |
|---|---|---|---|---|---|---|
| 21:00, 1 січня 2009 | Fabaceae 6 in Soil 190x289.jpg (файл) |  | 6 КБ | WikiSysop | 1 | |
| 20:56, 1 січня 2009 | Fabaceae 5 Flowering in vitro 200x289.jpg (файл) |  | 8 КБ | WikiSysop | 1 | |
| 20:50, 1 січня 2009 | Fabaceae 7 07.gif (файл) | 132 байтів | WikiSysop | 1 | ||
| 20:49, 1 січня 2009 | Fabaceae 7 06.gif (файл) | 879 байтів | WikiSysop | 1 | ||
| 20:47, 1 січня 2009 | Fabaceae 7 05.gif (файл) | 526 байтів | WikiSysop | 1 | ||
| 20:45, 1 січня 2009 | Fabaceae 7 04.gif (файл) |  | 439 байтів | WikiSysop | 1 | |
| 20:30, 1 січня 2009 | Fabaceae 7 01.gif (файл) | 98 байтів | WikiSysop | 1 | ||
| 20:29, 1 січня 2009 | Fabaceae 7 02.gif (файл) | 465 байтів | WikiSysop | 1 | ||
| 20:25, 1 січня 2009 | Fabaceae 7 03.jpg (файл) |  | 2 КБ | WikiSysop | 1 | |
| 20:22, 1 січня 2009 | Fabaceae 4 Regeneration 300x289.jpg (файл) |  | 8 КБ | WikiSysop | 1 | |
| 20:00, 1 січня 2009 | Fabaceae 3 Selection 300x263.jpg (файл) |  | 8 КБ | WikiSysop | 1 | |
| 19:52, 1 січня 2009 | Fabaceae 2 Protoplasts 300x192.jpg (файл) |  | 7 КБ | WikiSysop | 1 | |
| 19:48, 1 січня 2009 | Fabaceae 1 Shooty 300x197.jpg (файл) |  | 6 КБ | WikiSysop | 1 | |
| 19:11, 1 січня 2009 | Gramineae PCR.jpg (файл) |  | 30 КБ | WikiSysop | 1 | |
| 18:43, 1 січня 2009 | Gramineae PCR 04.jpg (файл) |  | 5 КБ | WikiSysop | 1 | |
| 18:38, 1 січня 2009 | Gramineae PCR 03.gif (файл) |  | 495 байтів | WikiSysop | 1 | |
| 18:35, 1 січня 2009 | Gramineae PCR 01.gif (файл) |  | 168 байтів | WikiSysop | 1 | |
| 18:33, 1 січня 2009 | Gramineae PCR 02.gif (файл) |  | 3 КБ | WikiSysop | 1 | |
| 18:25, 1 січня 2009 | Gramineae Rooting 126x184.jpg (файл) |  | 4 КБ | WikiSysop | 1 | |
| 17:42, 1 січня 2009 | Gramineae Regenerarion 274x224.jpg (файл) |  | 5 КБ | WikiSysop | 1 | |
| 17:42, 1 січня 2009 | Gramineae GUS 230x224.jpg (файл) |  | 2 КБ | WikiSysop | 1 | |
| 17:41, 1 січня 2009 | Gun 175x224.jpg (файл) |  | 4 КБ | WikiSysop | 1 | |
| 17:39, 1 січня 2009 | Gramineae Callus 300x213.jpg (файл) | | 9 КБ | WikiSysop | 1 | |
| 17:38, 1 січня 2009 | Gramineae Spike 300x312.jpg (файл) |  | 6 КБ | WikiSysop | 1 | |
| 14:29, 1 січня 2009 | Line Conversion 003.jpg (файл) |  | 11 КБ | WikiSysop | 1 | |
| 14:25, 1 січня 2009 | Line Conversion 040.gif (файл) |  | 2 КБ | WikiSysop | 1 | |
| 14:22, 1 січня 2009 | Line Conversion 031.gif (файл) |  | 118 байтів | WikiSysop | 1 | |
| 14:21, 1 січня 2009 | Line Conversion 039.gif (файл) |  | 2 КБ | WikiSysop | 1 | |
| 14:13, 1 січня 2009 | 5GUS 350x263.jpg (файл) |  | 7 КБ | WikiSysop | 1 | |
| 14:05, 1 січня 2009 | Line Conversion 038.gif (файл) |  | 2 КБ | WikiSysop | 1 | |
| 14:02, 1 січня 2009 | Line Conversion 034.gif (файл) |  | 805 байтів | WikiSysop | 1 | |
| 14:01, 1 січня 2009 | Line Conversion 037.gif (файл) |  | 2 КБ | WikiSysop | 1 | |
| 13:54, 1 січня 2009 | 6Primary transformant 350x234.jpg (файл) |  | 10 КБ | WikiSysop | 1 | |
| 13:46, 1 січня 2009 | Line Conversion 036.gif (файл) |  | 2 КБ | WikiSysop | 1 | |
| 13:44, 1 січня 2009 | Line Conversion 029.gif (файл) |  | 114 байтів | WikiSysop | 1 | |
| 13:42, 1 січня 2009 | Line Conversion 033.gif (файл) |  | 2 КБ | WikiSysop | 1 | |
| 13:37, 1 січня 2009 | Line Conversion 035.gif (файл) |  | 2 КБ | WikiSysop | 1 | |
| 13:20, 1 січня 2009 | Regeneration 350x263.jpg (файл) |  | 6 КБ | WikiSysop | 1 | |
| 13:13, 1 січня 2009 | Selection 350x263.jpg (файл) |  | 6 КБ | WikiSysop | 1 | |
| 12:39, 1 січня 2009 | CC 022.jpg (файл) |  | 3 КБ | WikiSysop | 1 | |
| 12:36, 1 січня 2009 | CC 023.gif (файл) |  | 153 байтів | WikiSysop | 1 | |
| 12:33, 1 січня 2009 | CC 018.jpg (файл) |  | 3 КБ | WikiSysop | 1 | |
| 12:31, 1 січня 2009 | CC 020.jpg (файл) |  | 2 КБ | WikiSysop | 1 | |
| 11:38, 1 січня 2009 | CT 015.gif (файл) |  | 236 байтів | WikiSysop | 2 | |
| 10:21, 1 січня 2009 | CT 011.gif (файл) |  | 401 байтів | WikiSysop | (Генетична трансформація пластидної ДНК) | 1 |
| 10:18, 1 січня 2009 | CT 012.gif (файл) |  | 404 байтів | WikiSysop | (Генетична трансформація пластидної ДНК) | 1 |
| 10:10, 1 січня 2009 | CT 013.gif (файл) |  | 427 байтів | WikiSysop | (Генетична трансформація пластидної ДНК) | 1 |
| 10:07, 1 січня 2009 | CT 009.gif (файл) |  | 283 байтів | WikiSysop | (для Генетична трансформація пластидної ДНК) | 1 |
| 08:47, 31 грудня 2008 | Postanova-SSSR 162x240.gif (файл) |  | 2 КБ | WikiSysop | 1 | |
| 08:44, 31 грудня 2008 | Postanova-Division 161x240.gif (файл) |  | 4 КБ | WikiSysop | 1 |
 Перша сторінка |
 Попередня сторінка |
 Наступна сторінка |
 Остання сторінка |